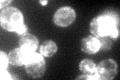
YGR157W
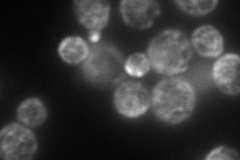
YGR157W
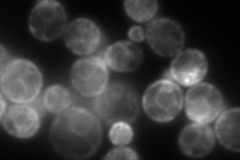
YGR157W
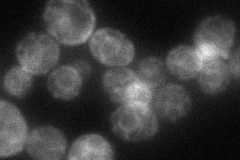
YGR157W
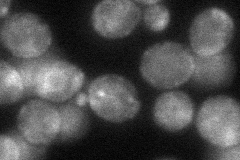
YGR157W
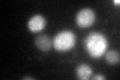
YGR157W
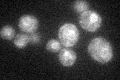
YGR157W

View description
Phosphatidylethanolamine methyltransferase (PEMT), catalyzes the first step in the conversion of phosphatidylethanolamine to phosphatidylcholine during the methylation pathway of phosphatidylcholine biosynthesis
Localization:
Intensity:
Fold change:
Significance:
-
C’ GFP library in SD
ER108.98 -
N' NOP1pr-GFP in SD
ER,bud147.489 -
N' TEF2pr-mCherry in SD
ER,punctate268.763 -
N' NATIVEpr-GFP in SD
ER59.2641 -
N' TEF2pr-VC and Cyto-VN in SD
ER,punctate52.2288 -
C’ GFP library in SD+DTT
ER60.590.55Yes -
C’ GFP library in SD+H2O2

ER67.810.62Yes -
C’ GFP library in Starvation Media
ER44.880.41Yes -
C’ GFP library on the background of Pup2-DaMP

ER -
C’ GFP library on the background of CCT mutant

ER90.34640.828922No
